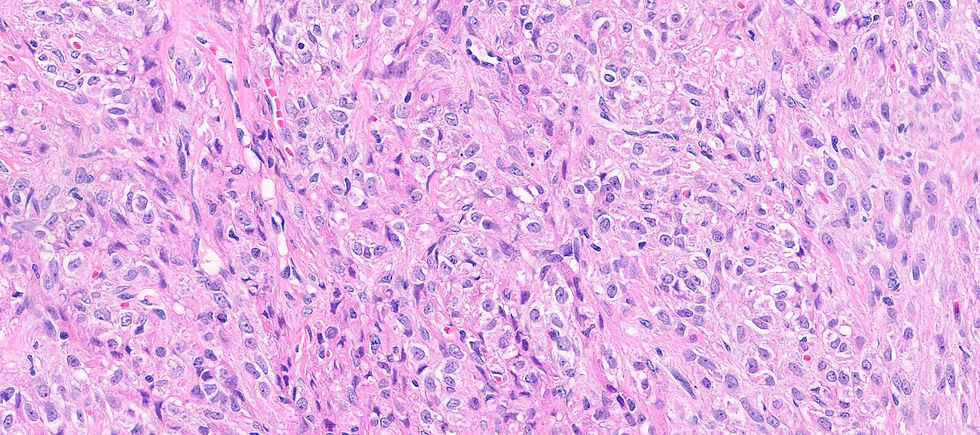
ree

Case 6
- Wangpan Shi
- Jan 6
- 1 min read
Updated: Jan 23
A 50-year-old women presented with abnormal uterine bleeding and she was found to have a large ovarian mass.

What is the diagnosis?
A: Perivascular epithelioid tumor
B: Endometrioid adenocarcinoma, FIGO3
C: Sclerosing stromal tumor
D: Steroid cell tumor
E: Leydig cell tumor
F: Granulosa cell tumor, adult type
G: Thecoma
Answer
Before showing the IHC, putting the tumor into sex-cord stromal category is correct. However, the large solid nest architecture with irregular spindle to oval nuclei may clue you in a certain entity.
A panel of two stains are showed below. What's the diagnosis?

reticulin 
Inhibin
Answer
The final answer is F. Adult granulosa cell tumor (AGCT). AGCT can show various morphological patterns however, the most common pattern is diffuse, but cells may be arranged in cords or trabeculae; large solid nest, or forming microfollicular pattern with Call–Exner bodies. Nuclei groove is a reliable feature but it is not always seen. In this case of luteinized tumor show abundant eosinophilic cytoplasm and often lack nuclear grooves. The tumor cells are positive for FOXL2, calretinin, inhibin (although staining may vary in distribution and intensity), and SF1. Reticulin surrounds groups of cells rather than single cell in thecoma or fibroma.
Case credit: UCSD Pathology
Author: Wangpan Jackson Shi, MD

Comments